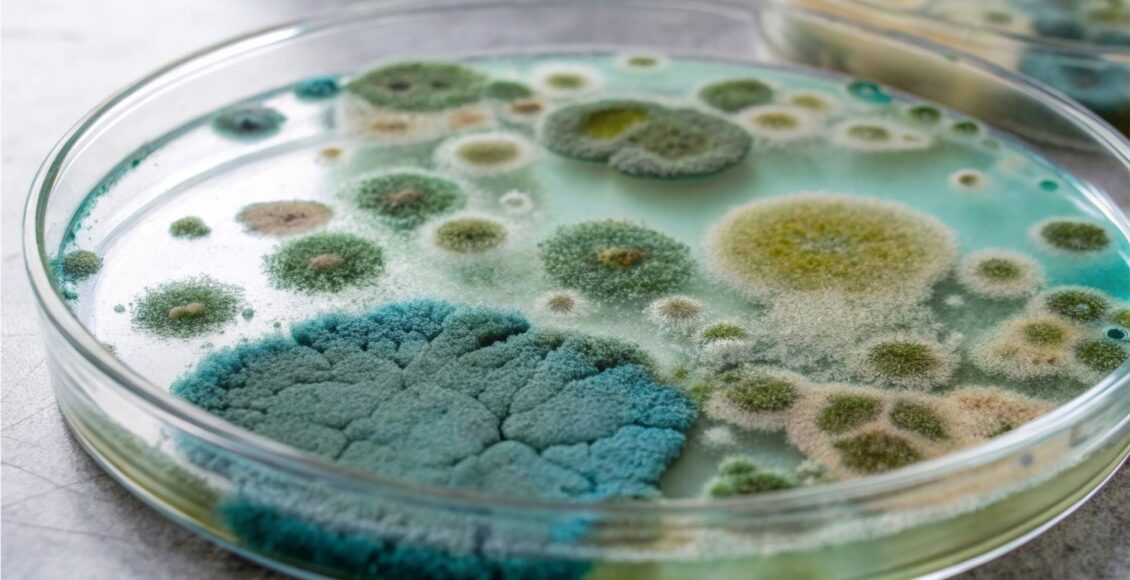

Micotoxinas no reguladas en los alimentos: un riesgo oculto
Las micotoxinas son compuestos tóxicos producidos por ciertos hongos que contaminan los cultivos antes o después de la cosecha
Cuando se habla de inocuidad alimentaria, el foco suele estar puesto en unas pocas toxinas bien conocidas: aflatoxinas, deoxinivalenol, ocratoxina A y otras de la misma familia. Estas micotoxinas están reguladas y monitoreadas rigurosamente a lo largo de toda la cadena alimentaria. Pero, ¿qué sucede con las demás? Investigaciones recientes muestran que existe un grupo creciente de micotoxinas no reguladas, compuestos tóxicos aún no son contemplados por la legislación, que están apareciendo con mayor frecuencia en alimentos.
Una revisión sistemática publicada en Toxins (2023) analizó más de 100 estudios realizados entre 2018 y 2022 para investigar la presencia global de 15 micotoxinas no reguladas en alimentos. Sus hallazgos ofrecen una actualización crítica sobre la situación actual y revelan vacíos importantes de información que es necesario abordar.
Las micotoxinas son compuestos tóxicos producidos por ciertos hongos que contaminan cultivos antes o después de la cosecha. Si bien muchas de ellas ya están sujetas a límites legales, otras, a pesar de su potencial toxicidad, aún no lo están. La razón es la falta de datos suficientes sobre su presencia o efectos.
En este grupo se encuentran compuestos como alternariol (AOH) y alternariol methyl ether (AME), producidas por el género Alternaria; enniatinas (ENNs), nivalenol (NIV), beauvericina (BEA), y moniliformina (MON), producidas por el género Fusarium; y esterigmatocistina (STC), producida principalmente por el género Aspergillus y considerada cancerígena. Estas toxinas han sido detectadas en cereales, frutas, vegetales, frutos secos, especias e incluso alimentos para lactantes. Algunas han demostrado tener efectos citotóxicos, genotóxicos o inmunotóxicos en estudios de laboratorio.
La revisión incluyó 108 estudios de 35 países, con datos predominantes de China, Italia, Nigeria, Corea del Sur y España. Los granos y los productos a base de granos (trigo, arroz, maíz, cebada y harinas) fueron los alimentos más estudiados, con 15 micotoxinas no reguladas analizadas, y también los más contaminados.
Otros grupos alimentarios en los que se hallaron frecuentemente estas toxinas incluyen legumbres, semillas oleaginosas, frutos secos, y alimentos destinados a bebés y niños pequeños. Sorprendentemente, también se detectaron en bebidas alcohólicas como sidra, vino y cerveza, así como en alimentos vegetales alternativos como hamburguesas de soja y bebidas de avena.
Uno de los aspectos más críticos del informe es la co-ocurrencia: la presencia simultánea de múltiples micotoxinas en un mismo producto. Se identificaron 38 combinaciones diferentes de dos o más micotoxinas no reguladas. El caso más extremo fue una muestra de sorgo de Etiopía que contenía 12 micotoxinas distintas.
Este análisis es importante porque cuando se combinan, estas toxinas pueden interactuar entre sí y potenciar su toxicidad. Algunas combinaciones provocan efectos aditivos o sinérgicos, como es el caso de BEA y ENB que tienen un efecto más tóxico sobre las células madre hematopoyéticas que cada toxina por separado. Por su parte, AOH y AME, pueden aumentar significativamente la muerte celular cuando se combinan.
A pesar del creciente interés, la investigación sobre estas toxinas enfrenta serios desafíos técnicos y regulatorios. El estudio destaca que la calidad de los datos es una barrera importante. La variabilidad en los métodos analíticos, la falta de materiales de referencia certificados y la inconsistencia en la forma de reportar los datos dificultan su comparación entre estudios.
Los autores proponen crear guías estandarizadas para el muestreo, análisis y presentación de resultados, además de monitorear de forma rutinaria las micotoxinas no reguladas, especialmente en alimentos de alto consumo como cereales, legumbres y productos infantiles.
Los cambios en temperatura y humedad en el conetxto del cambio climático pueden alterar la distribución geográfica de los hongos productores de micotoxinas, aumentando la probabilidad de que aparezcan nuevas toxinas emergentes y la necesidad de una vigilancia continua.
Gestionar adecuadamente los riesgos de estas micotoxinas no reguladas requiere de la colaboración internacional, el intercambio científico y la adopción de políticas basadas en evidencia. En ese sentido, en 2022, la Unión Europea estableció niveles indicativos para AOH, AME y TeA en ciertos productos.
Lograr establecer niveles seguros de exposición y una mejor armonización de los métodos analíticos ayudaría a las agencias regulatorias a evaluar el riesgo con mayor precisión.
